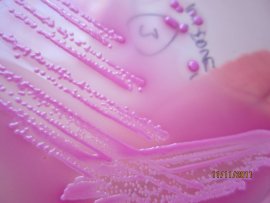
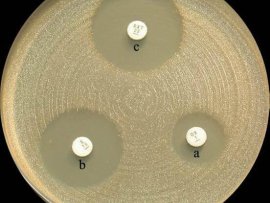
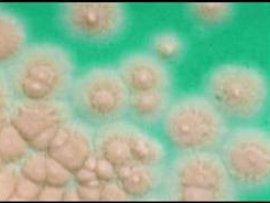

Mikrobiologie
tel. 465 710 550
Oddělení lékařské mikrobiologie (OLM) je součástí laboratorního komplementu Nemocnice Pardubického kraje, a. s., Orlickoústecké nemocnice, který je vzájemně propojen společným laboratorním informačním systémem OpenLims.
OLM provádí základní a speciální mikrobiologická vyšetření biologických materiálů humánního i animálního původu, vody, stěrů z prostředí apod.
Vedle této činnosti se podílí na zajištění odběrů, organizaci transportu biologického materiálu a konzultační činnosti v oblasti laboratorní medicíny, antibiotické politiky. Nedílnou součástí je podíl na výuce a zaškolování pracovníků laboratorních oborů. OLM poskytuje služby pro akutní lůžkovou péči, následnou lůžkovou péči a ambulantní specialisty a praktické lékaře.
Naše subspecializace:
- bakteriologie,
- mykobakteriologie,
- základní mykologie,
- virologie (omezené spektrum vyšetření),
- PCR (omezené spektrum vyšetření)
- parazitologie,
- antibiotické středisko s konzultační a konziliární službou,
- pneumologická cytologie.
Nabízíme praxe pro studenty SŠ i VŠ. Více informací u vedoucí laborantky na telefonu +420 465 710 551.
Laboratoř
Adresa:
Pracoviště ALBERTINUM
Za Kopečkem 353, 564 01 Žamberk
Telefon: +420 465 710 552/550
E-mail: jirina.jiresova@nempk.cz
Provozní doba, příjem materiálu
| všední dny | 7.00–15.30 |
| sobota | 6.30–13.00 |
| neděle | 6.30–14.30 |
| svátky | 6.30–12.00 |